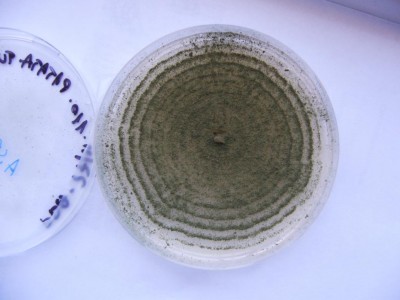
aspergillus sp..JPG (71.36 KiB) Osservato 997 volte aspergillus sp..JPG

Sperando di far cosa utile e istruttiva metto, come promesso, foto di monilia (quasi sicuramente
Monilia laxa) in coltura su piastra. Si scorgono i 5 frammenti prelevati dal campione che portai del mio albicocco: quello a dx è oramai inquinato, quelli migliori sono al centro e in alto e in basso; deve però trascorrere qualche altro giorno affinché la colonia acquisti la sua forma tipica, utile per la determinazione del fungo stesso.
L'isolamento su terreno di coltura è un mezzo diagnostico tradizionale, relativamente semplice e poco costoso, e permette di poter isolare in purezza un patogeno mediante passaggi successivi (metto foto di un
Aspergillus sp. trovato su patate malamente immagazzinate) da cui allestire vetrini per diagnosi microscopica e/o proseguire con analisi di tipo molecolare (ciò permette di dissipare eventuali dubbi sulla specie e/o sulla varietà patologica).
Se all'Università mi faranno una diagnosi PCR vedrò possibilmente di postare foto significative di tale mezzo diagnostico moderno.
- Allegati
-

-